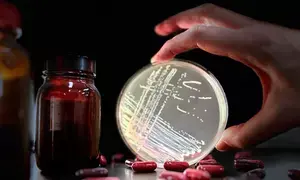
Superbug-killing virus discovered in Australian creek

ARCHIVE SiteMap 2024-11-06
 Report shows inequality, risk of poverty hardly change in Germany
Report shows inequality, risk of poverty hardly change in Germany Telugu-origin Usha Chilukuri set to become ‘Second Lady’ of US
Telugu-origin Usha Chilukuri set to become ‘Second Lady’ of US Superbug-killing virus discovered in Australian creek
Superbug-killing virus discovered in Australian creek Have no illusions regarding US President-elect, says Russia after Trump's triumph
Have no illusions regarding US President-elect, says Russia after Trump's triumph Weather Dept issues yellow alert in TN for next 24 hours
Weather Dept issues yellow alert in TN for next 24 hours The Incredible Health Benefits of Tulsi Water: A Natural Morning Ritual
The Incredible Health Benefits of Tulsi Water: A Natural Morning Ritual Poona Club Open: Karandeep Kochhar, Kshitij Naveed Kaul fire 64 each for joint lead
Poona Club Open: Karandeep Kochhar, Kshitij Naveed Kaul fire 64 each for joint lead Bengaluru woman alleges sexual harassment by bicycle rider
Bengaluru woman alleges sexual harassment by bicycle rider Work for revival of Kolkata’s iconic Adi Ganga to start from January
Work for revival of Kolkata’s iconic Adi Ganga to start from January Drug smuggler's property worth Rs 1.2 crore seized in J&K's Anantnag
Drug smuggler's property worth Rs 1.2 crore seized in J&K's Anantnag Plans needed to develop new industrial townships: Haryana Minister
Plans needed to develop new industrial townships: Haryana Minister Tata Steel bounces back with Rs 833 crore net profit in Q2
Tata Steel bounces back with Rs 833 crore net profit in Q2